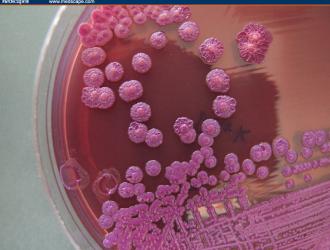

«Lo chiamano Indra, Mitra, Varuṇa, Agni ed egli è anche Garutmān celeste dalle splendide ali. I saggi chiamano l’unico essere in molti modi: lo chiamano Agni, Yama, Mātariśvan» (índram mitráṃ váruṇam agním āhur átho divyáḥ sá suparṇó garútmān / ékaṃ sád víprā bahudhā́ vadanty agníṃ mātaríśvānam āhuḥ, ṚV...
India
Senza un taglio consistente delle emissioni di gas serra, entro cinquant’anni le aree del Pianeta abitate da un terzo degli esseri umani si riscalderanno tanto quanto le parti più calde del deserto del Sahara. Pertanto, 3,5 miliardi di persone potrebbero ritrovarsi in condizioni quasi invivibili...
Sessantasei milioni di alberelli piantati in mezza giornata da circa un milione e mezzo di volontari.
È successo in India, precisamente nello stato di Madhya Pradesh, circa due settimane fa.
Un evento che, certificato dal Guinness dei...
INDIA - Dall'Oriente asiatico sembra arrivare una prima ma significativa esperienza concreta di sviluppo dell'agricoltura 100% bio. Il piccolo stato del Sikkim, che si trova nell'estremità nord-orientale del sub-continente indiano, al confine con la Cina e tra Nepal e Bhutan, ha infatti...
INDIA - Negli ultimi giorni la notizia di un nuovo batterio particolarmente virulento, ma già conosciuto negli ambienti di ricerca, sta rimbalzando sulle riviste specializzate. La melioidosi, una malattia altamente contagiosa, è ampiamente diffusa in India, secondo un nuovo rapporto dei ricercatori dell'...